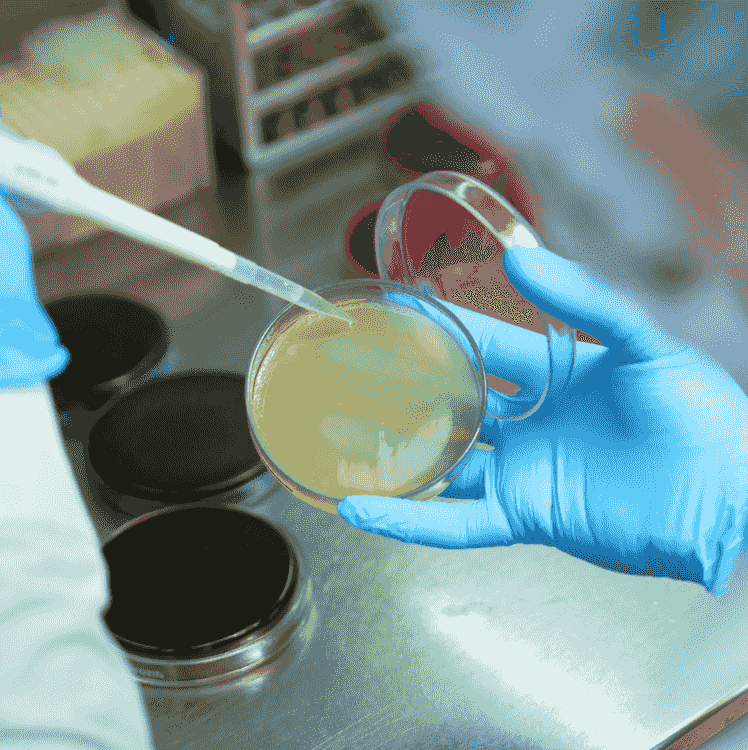
points
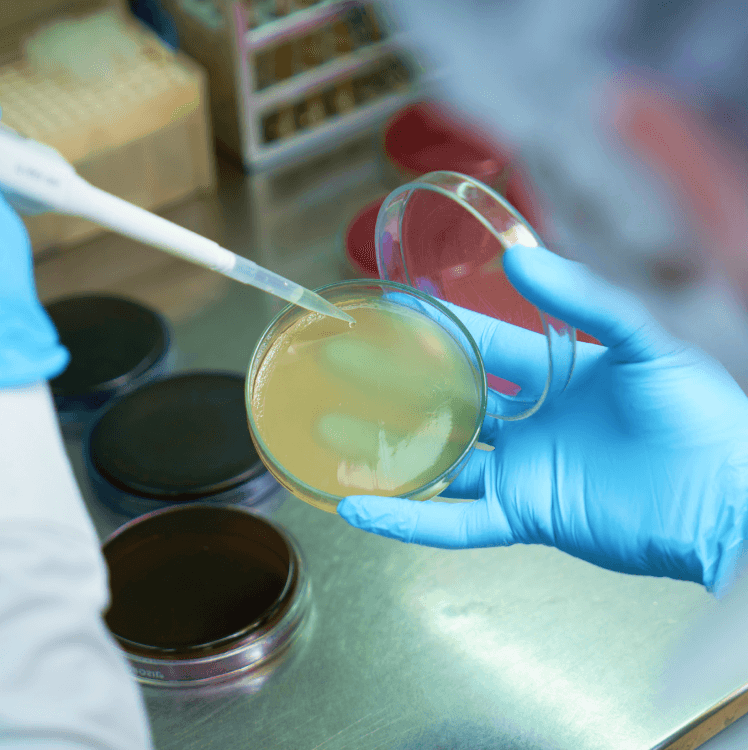
points

The Sky
isn’t the Limit
for Fine Dining

50+
Years of Experience

2100+
Employees

11
Locations

50+
Premium Clients
Who we are
What defines CAFS is not just our food, but the seamless execution of our services. For us, food safety, hygiene and quality are paramount. We are delighted to deliver gourmet catering experiences of the highest calibre.What defines CAFS is not just our food, but the seamless execution of our services. For us, food safety, hygiene and quality are paramount. We are delighted to deliver gourmet catering experiences of the highest calibre.
We Deliver
We follow industry-standards quality checks for safety and acceptance of every meal served.
We Ensure
Our team ensures a dependable and unmatched premium catering experience for your customers.
We serve
Travel Catering
Soar to new culinary heights with our travel catering services. With attention to detail and top-notch service, passengers will experience an excellent gourmet menu that reflects the prestige of your company. Our meticulously crafted menus feature premium ingredients and accommodate diverse preferences, placing special emphasis on freshness, safety and quality.
LEARN MORE about Travel CateringCorporate & Institutional Catering
We understand the unique demands of professional, institutional and educational realms. CAFS finds delight in curating safe and healthy culinary experiences that not only meet but exceed expectations.
LEARN MORE about Corporate & Institutional CateringRetail Store Catering
Our retail catering services offer a delightful blend of health and taste for your shelves. At CAFS, we understand the significance of offering your customers nourishing and wholesome options. Our commitment to excellence is reflected in every carefully prepared food item, whether it’s a wholesome meal, a simple snack or anything in between. We are setting a new standard for quality in retail catering.
LEARN MORE about Retail Store CateringWhat make us different
Sculpting a Legacy in Fine Catering


Procuring Superior
Ingredients
Freshness and Quality - Our benchmarks for selecting the best ingredients.


Hygeine & Safety
Protecting flavours while ensuring the highest standards in food safety.


Culinary
Craftsmanship
Experience a sky-high journey of culinary expertise with CAFS.


Effective
Temperature control
Locking in the freshness to provide a flavourful delight in every meal.


Inventory
Management
Managing inventory to ensure the best ingredient finds its rightful place.

Quality Assurance
Preserving quality in every bite for the finest dining experience.


Perfection in
Preservation
Setting new standards of catering hygiene through mechanised cleaning.
Latest
From
Insights




6 Jun 2024
CAFS has continued to grow to greater heights and has always endeavored to offer all its customers.


19 Apr 2024
Nutritional Considerations: How to Pick Inflight Meals That Suit Your Dietary Needs